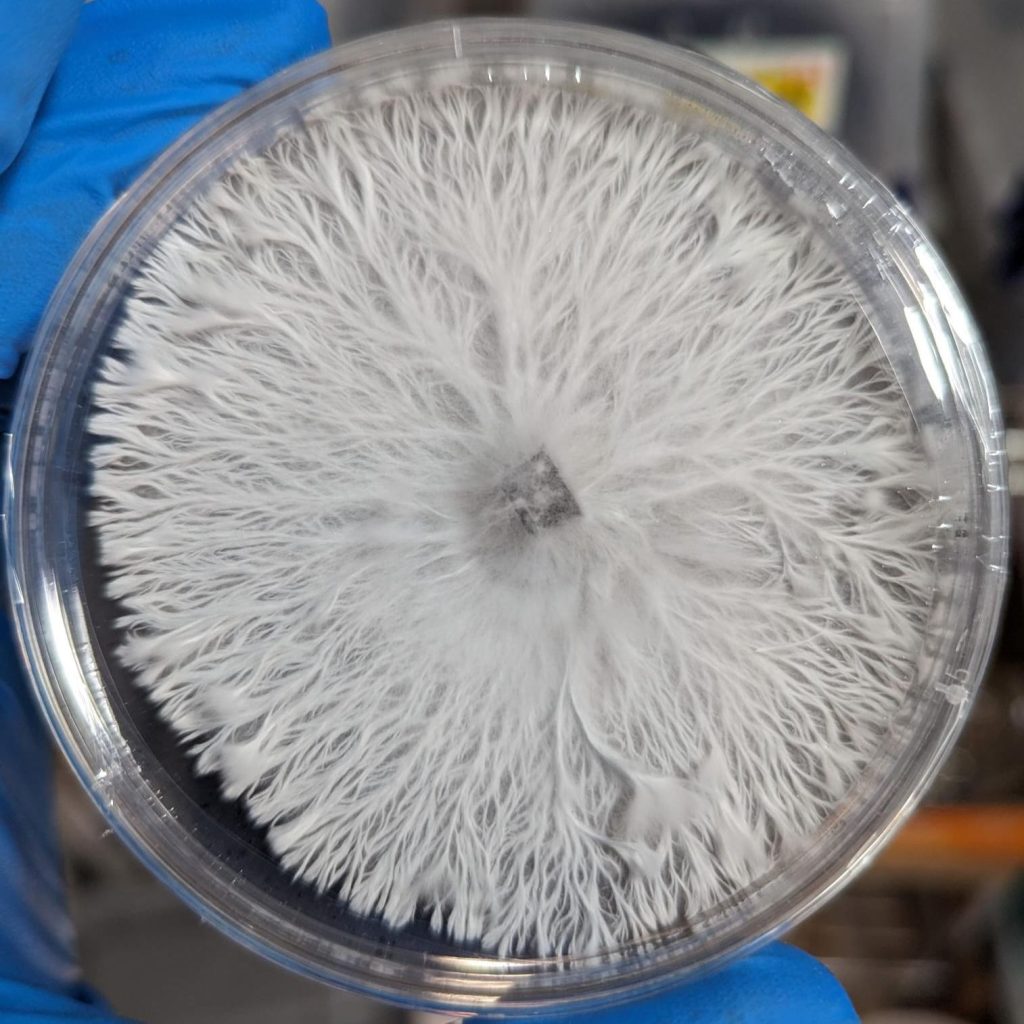

Welcome to the Woodlands!
Woodland Formations Products
-
 Gourmet/Medicinal Liquid CulturesPrice range: $9.99 through $14.99
Gourmet/Medicinal Liquid CulturesPrice range: $9.99 through $14.99 -
 Active Liquid CulturesPrice range: $19.99 through $24.99
Active Liquid CulturesPrice range: $19.99 through $24.99 -
 Cubensis Spore SolutionsPrice range: $5.99 through $7.99
Cubensis Spore SolutionsPrice range: $5.99 through $7.99
Here at the Woodland Formations Shop, we are dedicated to offering laboratory grade mushroom genetics for microscopy and mycology enthusiasts alike. From ease of use to a broad range of products at basement level prices, we have YOU (Yes, I’m talking to you hot stuff!) covered.
All of the products here at the shop are prepared in a HEPA filtered clean room suited with industrial grade 99.99% efficient at 0.03 micron HEPA filtration fans, all of our gourmet and medicinal varieties are tested for viability and vigor (Active spores are viewed under a 400X – 2500X trinocular compound microscope to confirm a successful microscopy/taxonomy session for the consumer). Join the never ending flow of happy customers we have here by selecting one of our proudly produced spore solutions, spore swabs or gourmet/medicinal liquid cultures!